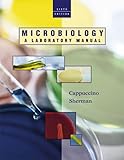
Amazon cover image

Microbiology : a laboratory manual / James G. Cappuccino, Natalie Sherman
Publication details: San Francisco : Benjamin Cummings, 2002Edition: 6th edDescription: xvi , 491 p. : ill. (some col.) ; 28 cmISBN:- 0805376488
- QW25
| Item type | Current library | Home library | Collection | Call number | Materials specified | Copy number | Status | Date due | Barcode | |
|---|---|---|---|---|---|---|---|---|---|---|
| AM | PERPUSTAKAAN DR ABDUL LATIFF | PERPUSTAKAAN DR ABDUL LATIFF KOLEKSI AM-P. DR ABDUL LATIFF | - | QW25.C249m 2002 (Browse shelf(Opens below)) | n.1 | 1 | Available | 00001558632 | ||
| AM | PERPUSTAKAAN TUN SERI LANANG | PERPUSTAKAAN TUN SERI LANANG KOLEKSI AM-P. TUN SERI LANANG (ARAS 5) | - | QR63.C34 2002 (Browse shelf(Opens below)) | 1 | Available | 00001327426 |
Browsing PERPUSTAKAAN TUN SERI LANANG shelves, Shelving location: KOLEKSI AM-P. TUN SERI LANANG (ARAS 5) Close shelf browser (Hides shelf browser)
| No cover image available |

|

|

|

|

|

|
||
| QR63.B7 Laboratory microbiology | QR63.C34 Microbiology : a laboratory manual / | QR63.C34 1996 Microbiology : a laboratory manual / | QR63.C34 2002 Microbiology : a laboratory manual / | QR63.C34 2005 Microbiology : a laboratory manual / | QR63.C34 2014 Microbiology : a laboratory manual / | QR63.D35 Microbiology : high-school science fair experiments / |
Includes index
There are no comments on this title.
Log in to your account to post a comment.